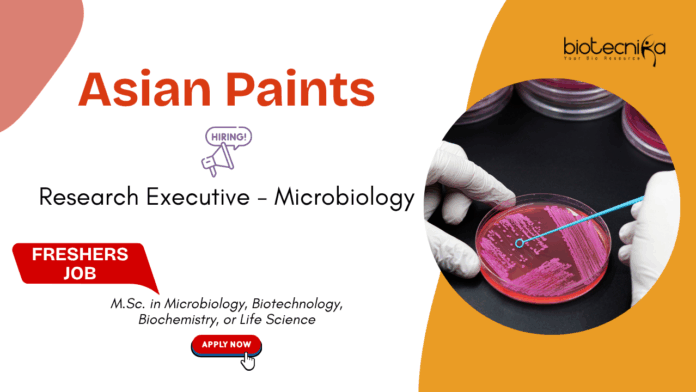

Microbiology Jobs For Freshers at Asian Paints | Apply Now For Research Executive Role
Asian Paints is hiring a Research Executive – Microbiology for its R&D facility in Navi Mumbai. This opening is ideal for candidates seeking microbiology jobs for freshers, especially those aiming to build a strong foundation in a research job within the industrial life sciences domain. If you hold an M.Sc. in Microbiology, Biotechnology, Biochemistry or any life sciences job stream, this opportunity offers hands-on lab exposure, microbial analysis, and career growth in one of India’s top companies.
- Job Title: Research Executive – Microbiology
- Job ID: 14006
- Location: Navi Mumbai, Maharashtra, India
- Department: Research & Technology
About the Company
Asian Paints is India’s largest paint and coatings company and a global leader in home décor and chemical innovation. With world-class R&D facilities and cutting-edge laboratory infrastructure, the company offers exceptional opportunities for young scientists exploring life sciences job openings or seeking advanced research jobs. Asian Paints fosters innovation, safety, and continuous learning, making it an ideal workplace for candidates pursuing microbiology jobs for freshers.
Job Purpose
The Research Executive will perform microbiological analyses on assigned samples, interpret results, maintain documentation, adhere to specifications, and support continuous improvement initiatives. This research job is suitable for candidates seeking to develop strong technical expertise while contributing to high-quality R&D outputs.
Key Responsibilities
- Perform microbiological testing as per proposals and document daily work accurately.
- Interpret scientific data and communicate findings to lab management.
- Initiate and investigate non-conformances, conduct root cause analysis, and assist with corrective action implementation.
- Maintain laboratory documentation and report deviations promptly.
- Conduct cultural confirmations to verify the purity and identity of microorganisms.
- Support corporate quality, safety, and continuous improvement programs.
- Execute assigned duties within timelines while following health and safety norms.
Key Performance Indicators
- Hands-on experience in isolation, purification, identification, and preservation of microorganisms.
- Strong written and verbal scientific communication skills.
- Ability to execute and document experiments accurately.
- Capability to interpret, analyse, and present scientific results.
- Proactiveness, teamwork, organisation, and time management abilities.
Qualifications
- Educational Requirement: M.Sc. in Microbiology, Biotechnology, Biochemistry, or any Life Science discipline.
- Experience: 0–2 years; suitable for microbiology jobs for freshers and early-career applicants.
- Additional Skills:
- Understanding of microbiology testing procedures
- Experience with microorganisms (Algae, Fungi, Bacteria) preferred
- Knowledge of paint preservatives is desirable
Functional Competencies
- Execution of microbiological test methods
- Identification and isolation of microbial species
- Ability to handle a variety of microorganisms safely and accurately
Additional Requirements
- Skills in molecular biology
- Data analysis capabilities
- Strong communication skills
If you’re looking for microbiology jobs for freshers that offer hands-on learning, advanced microbial testing, and exposure to industry-grade research. In that case, this Asian Paints research job is a strong fit. Candidates from microbiology and life sciences backgrounds can build a promising career while working with one of India’s top R&D-driven companies.